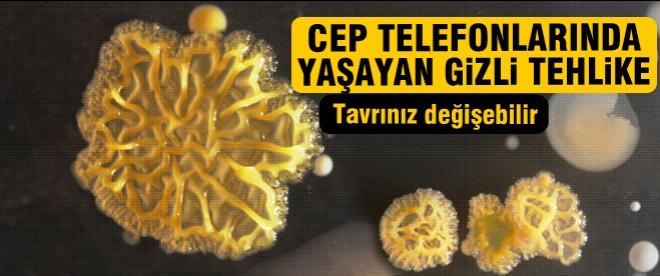

Şöförsüz otomobiller konusunda çalışmalar yapılıyor olsa da henüz uygulamaya geçilecek seviyeye ulaşılmadı. Ancak geliştirilen teknolojilerin kısmen de olsa kullanıma girmesi mümkün.
Örneğin, Bosch tarafından geliştirilen bir sistem, cep telefonu uygulamalarını kullanarak otomobilinizi sizin için park edebiliyor.